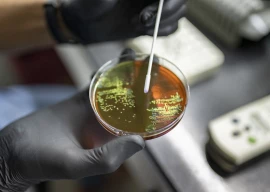

Ismail Rasheed, known locally as the blogger "Hilath," was on his way home from prayers on the evening of June 4 when three men grabbed him from behind and one of them stabbed him in the throat.
The 37-year-old former journalist with leading daily Haveeru, who had upset the Indian Ocean nation's increasingly influential religious hardliners, slumped in a pool of blood outside his front door in the capital Male.
Rushed to hospital, he remained in intensive care for days where doctors brought him back from the brink. His trachea -- but not a vital artery -- had been sliced clean through.
"I was attacked because I advocate secularism. The radicals want Maldives to remain a 100-percent Islamic country," he told AFP in an interview conducted via Twitter and email in the past few weeks.
The free-speech advocate has been literally silenced. He was unable to talk in person or over the telephone because doctors have advised him not to speak while his throat heals.
Fearful for his future safety, Rasheed has since fled the country and is considering seeking political asylum.
"The Maldives is not safe for me anymore," he said, declining to disclose his present whereabouts.
His attempted murder, he is convinced, was linked to the political and social changes sweeping the Indian Ocean island nation, a "paradise" holiday destination of turquoise waters and coral-fringed beaches.
The country's first democratically elected president, the Western-educated former political prisoner Mohamed Nasheed, was ousted in February after a mutiny by police and army officers which he and his supporters view as a coup.
Former vice president Mohamed Waheed was quickly installed as head of state, sparking protests which continue to this day as well as a wave of political violence.
Visiting tourists -- celebrities and well-heeled honeymooners who head for secluded luxury hotels on outlying islands -- are blissfully unaware. They are kept deliberately out of the cramped capital of Male and other populated areas.
One consequence of the change in power has been an increased role for the ultra-conservative Adhaalath Party, whose supporters follow a strict brand of Wahhabi Islam from the Gulf that has grown steadily in recent decades.
The party has two ministers in Waheed's administration.
Adhaalath regularly accused Nasheed during his time in office of having links to Jews and Christians and it helped spur protests against him in the months leading to his ousting.
"Ever since the radicals got affiliated with Waheed, freedom of speech has deteriorated," explained Rasheed, a distant relative of Nasheed and a follower of Sufi Islam, a more mystical and moderate form of the religion.
The idea of his blog was "to criticise Islamic extremists and Gayoom," he said referring to former strongman Maumoon Abdul Gayoom who ruled the country for three decades until the first free elections in 2008.
Even during Nasheed's time, Rasheed received death threats, was arrested and had his website closed down by the Islamic affairs ministry. Last December, his skull was fractured by thugs during a rally for religious tolerance.
Human Resources and Youth Minister Mohamed Shareef condemned the stabbing in an interview with AFP shortly afterwards, but he also implied that Rasheed should have known he had become a target.
"We are not a secular country. When you talk about religion there will always be a few people who do not agree," he said.
The Maldives, despite the welcome given to hedonistic tourists from the West, is an Islamic republic where openly practising another religion is illegal under its Sharia law, as is drinking alcohol and adultery.
President Waheed's office insists that the attack on Rasheed was gang-related.
"It had nothing to do with religious extremism or his work as a journalist," presidential spokesman Masood Imad told AFP by telephone.
"He is a member of a gang and had been attacked by rival gang members in the past too. It is unfair to blame this attack on anything else," Imad said.
Rasheed says police have identified the "Islamic extremists" responsible for slitting his throat -- "they came to show me their photos" -- but no arrests have been made.
Former president Nasheed, who continues to campaign for early elections in the Maldives, is adamant that his flight from the country is emblematic of the worrying restrictions on free-speech.
"It is very much under threat now. Of course Hilath had views that the vast majority of Maldivians couldn't digest, but that is not the issue. Everyone should be able to express their views," he told AFP.

COMMENTS
Comments are moderated and generally will be posted if they are on-topic and not abusive.
For more information, please see our Comments FAQ